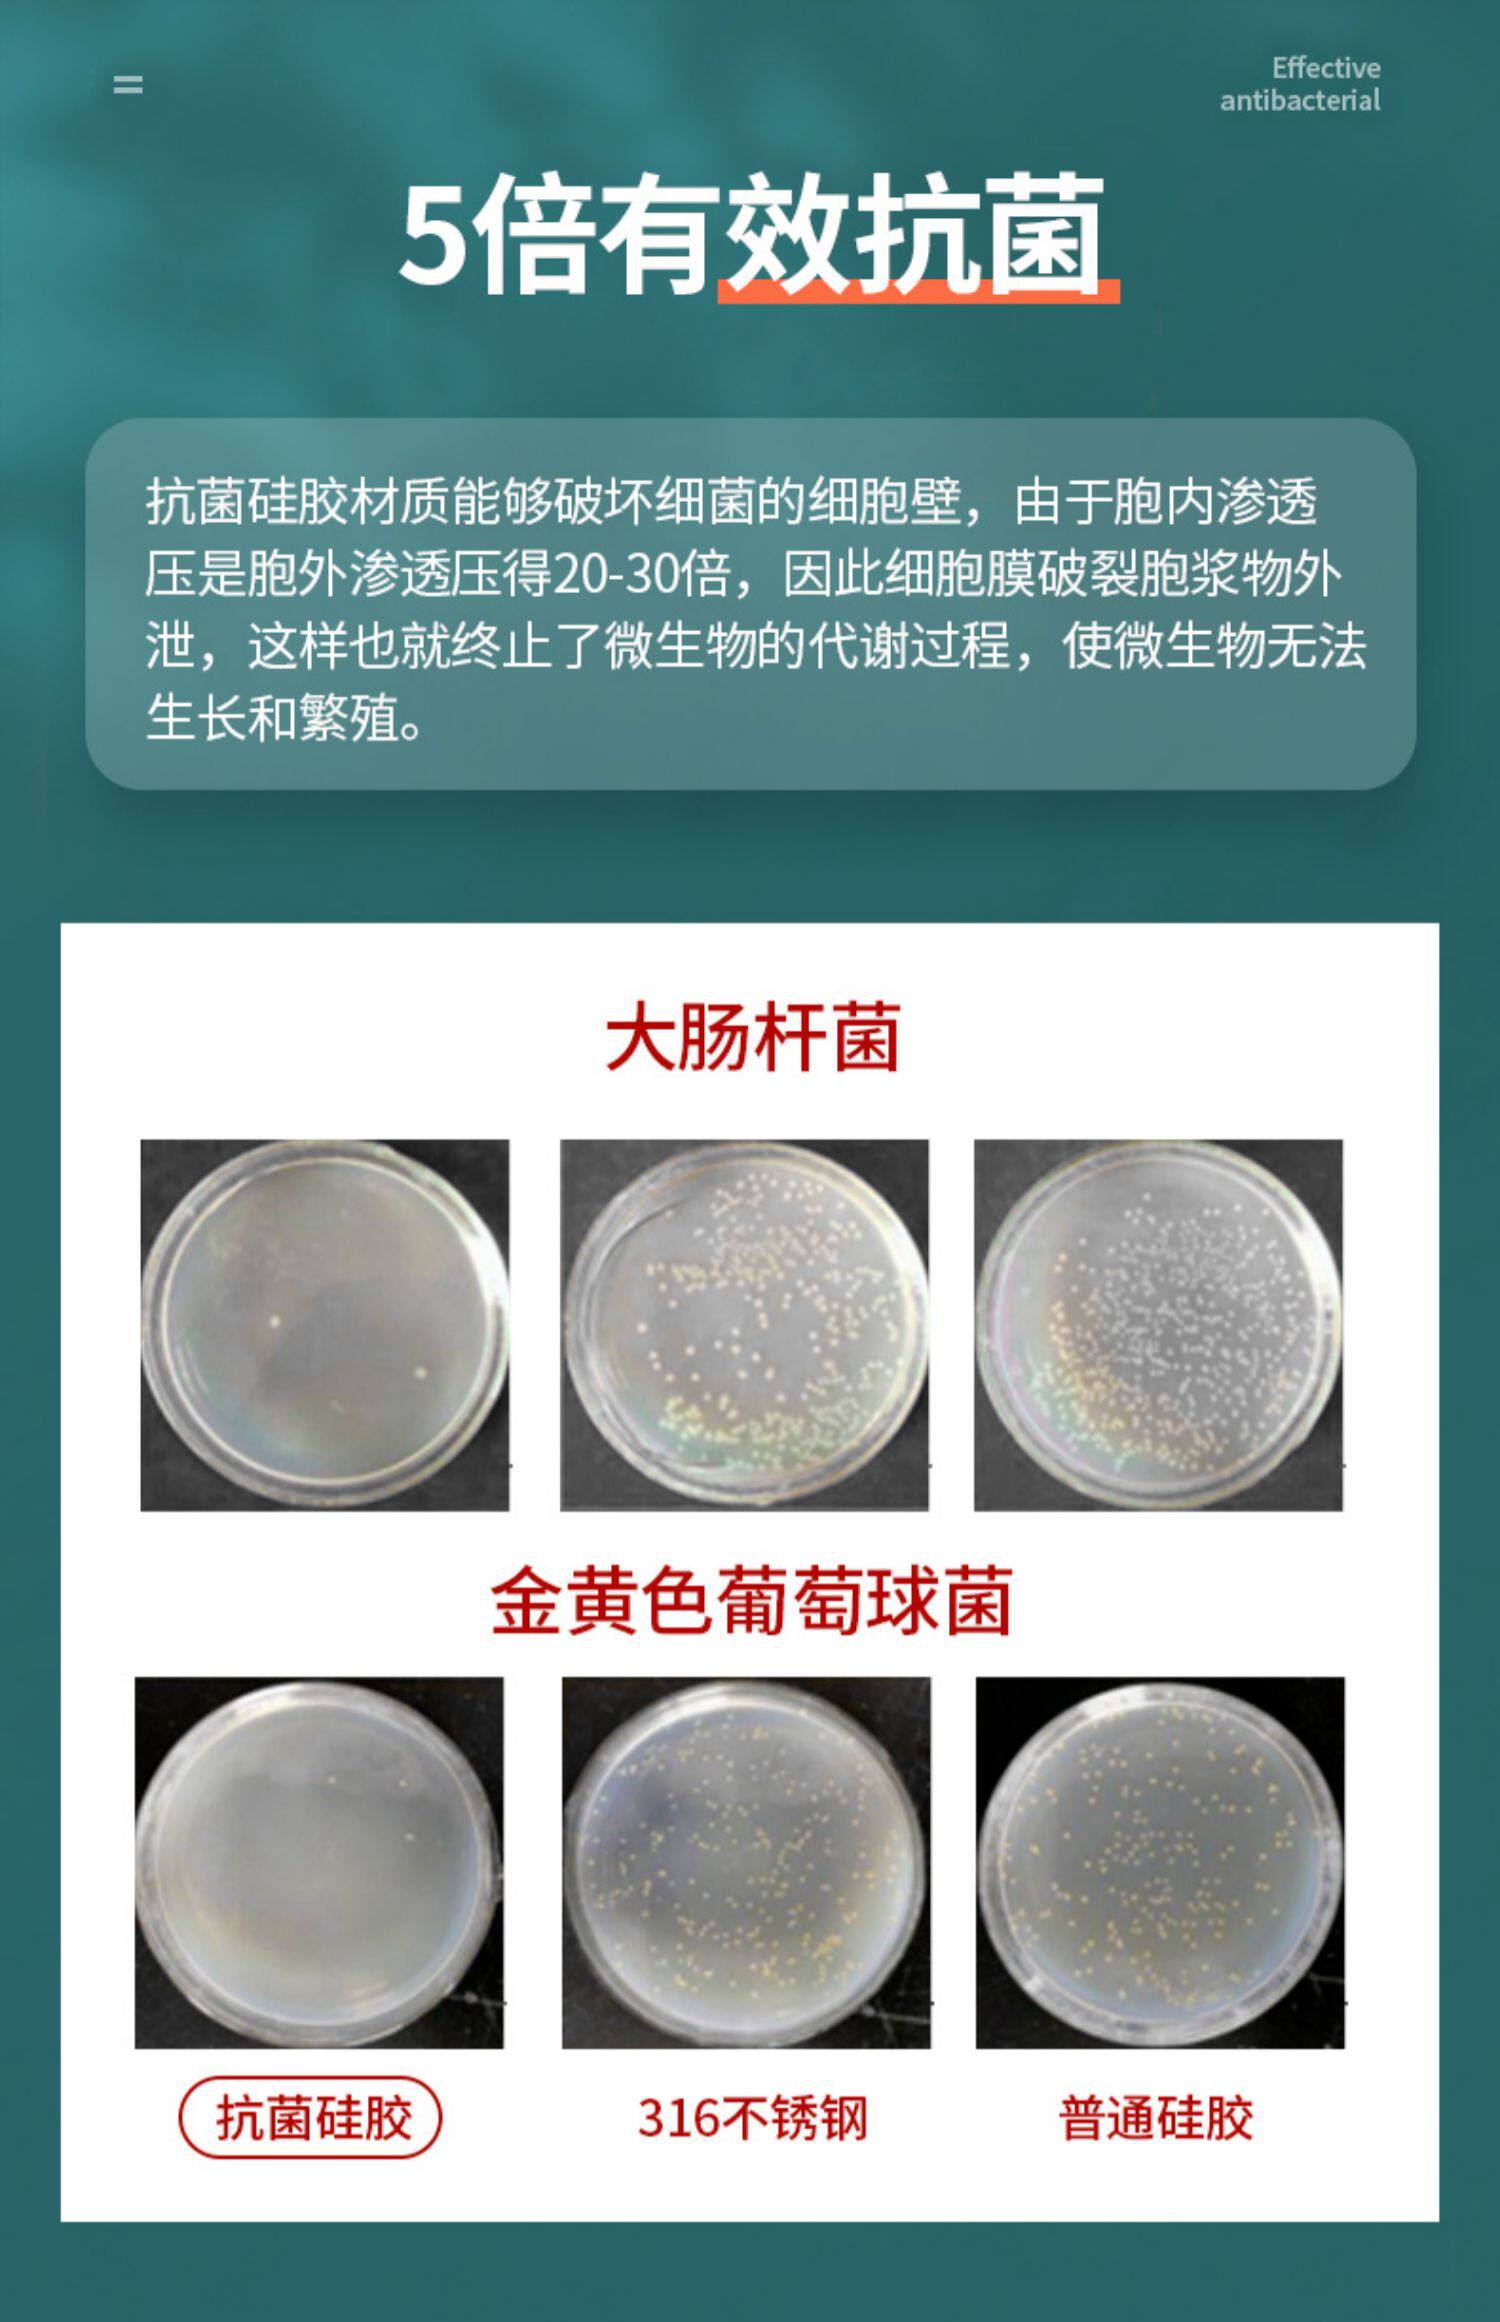

Силиконовый шпатель, нежигальный горшок, специальная лопата с высокой температурой домашней шрифт -фарма

Цена: 315-907руб. (¥14.9)
Артикул: 649443098908
Вес товара: ~0.7 кг. Указан усредненный вес, который может отличаться от фактического. Не включен в цену, оплачивается при получении.
Описание товараPGRpdj48aW1nIHNyYz0iaHR0cHM6Ly9pbWcuYWxpY2RuLmNvbS9pbWdleHRyYS9pMi8zNjMxNTgyODcvTzFDTjAxRm9oZUhmMkI1VXQxWTBRYXNfISEzNjMxNTgyODcuanBnIj48L2Rpdj48ZGl2PjxpbWcgc3JjPSJodHRwczovL2ltZy5hbGljZG4uY29tL2ltZ2V4dHJhL2k0LzM2MzE1ODI4Ny9PMUNOMDFzTUJUSWsyQjVVc215U3lGNF8hITM2MzE1ODI4Ny5qcGciPjwvZGl2PjxkaXY+PGltZyBzcmM9Imh0dHBzOi8vaW1nLmFsaWNkbi5jb20vaW1nZXh0cmEvaTEvMzYzMTU4Mjg3L08xQ04wMUlnOUtUZzJCNVVzdDRtRmdJXyEhMzYzMTU4Mjg3LmpwZyI+PC9kaXY+PGRpdj48aW1nIHNyYz0iaHR0cHM6Ly9pbWcuYWxpY2RuLmNvbS9pbWdleHRyYS9pNC8zNjMxNTgyODcvTzFDTjAxYkszNTdJMkI1VXN0Z1lWTXNfISEzNjMxNTgyODcuanBnIj48L2Rpdj48ZGl2PjxpbWcgc3JjPSJodHRwczovL2ltZy5hbGljZG4uY29tL2ltZ2V4dHJhL2kxLzM2MzE1ODI4Ny9PMUNOMDFaZWM1MWwyQjVVdDJLemVuOV8hITM2MzE1ODI4Ny5qcGciPjwvZGl2PjxkaXY+PGltZyBzcmM9Imh0dHBzOi8vaW1nLmFsaWNkbi5jb20vaW1nZXh0cmEvaTIvMzYzMTU4Mjg3L08xQ04wMWE5NnF2NDJCNVVzeU9PckE3XyEhMzYzMTU4Mjg3LmpwZyI+PC9kaXY+PGRpdj48aW1nIHNyYz0iaHR0cHM6Ly9pbWcuYWxpY2RuLmNvbS9pbWdleHRyYS9pNC8zNjMxNTgyODcvTzFDTjAxcVE1Q01VMkI1VXQwckxPaDlfISEzNjMxNTgyODcuanBnIj48L2Rpdj48ZGl2PjxpbWcgc3JjPSJodHRwczovL2ltZy5hbGljZG4uY29tL2ltZ2V4dHJhL2kzLzM2MzE1ODI4Ny9PMUNOMDFxaG9LS0kyQjVVc3ZpakhRUV8hITM2MzE1ODI4Ny5qcGciPjwvZGl2PjxkaXY+PGltZyBzcmM9Imh0dHBzOi8vaW1nLmFsaWNkbi5jb20vaW1nZXh0cmEvaTEvMzYzMTU4Mjg3L08xQ04wMXdtQldBYjJCNVV0MzZ1WWxkXyEhMzYzMTU4Mjg3LmpwZyI+PC9kaXY+PGRpdj48aW1nIHNyYz0iaHR0cHM6Ly9pbWcuYWxpY2RuLmNvbS9pbWdleHRyYS9pMS8zNjMxNTgyODcvTzFDTjAxNXVsaThPMkI1VXQyT0JFYU1fISEzNjMxNTgyODcuanBnIj48L2Rpdj48ZGl2PjxpbWcgc3JjPSJodHRwczovL2ltZy5hbGljZG4uY29tL2ltZ2V4dHJhL2kxLzM2MzE1ODI4Ny9PMUNOMDFDUlZGV08yQjVVc3gwNTFtU18hITM2MzE1ODI4Ny5qcGciPjwvZGl2PjxkaXY+PGltZyBzcmM9Imh0dHBzOi8vaW1nLmFsaWNkbi5jb20vaW1nZXh0cmEvaTIvMzYzMTU4Mjg3L08xQ04wMU1rd2h4bzJCNVVzeVJXczllXyEhMzYzMTU4Mjg3LmpwZyI+PC9kaXY+PGRpdj48aW1nIHNyYz0iaHR0cHM6Ly9pbWcuYWxpY2RuLmNvbS9pbWdleHRyYS9pMy8zNjMxNTgyODcvTzFDTjAxV3BwRFk1MkI1VXN0Z1hkTHlfISEzNjMxNTgyODcuanBnIj48L2Rpdj48ZGl2PjxpbWcgc3JjPSJodHRwczovL2ltZy5hbGljZG4uY29tL2ltZ2V4dHJhL2k0LzM2MzE1ODI4Ny9PMUNOMDFUbk51QncyQjVVc3Q0bzNzbV8hITM2MzE1ODI4Ny5qcGciPjwvZGl2PjxkaXY+PGltZyBzcmM9Imh0dHBzOi8vaW1nLmFsaWNkbi5jb20vaW1nZXh0cmEvaTIvMzYzMTU4Mjg3L08xQ04wMW9hcUlkNTJCNVVzbXlTVkE2XyEhMzYzMTU4Mjg3LmpwZyI+PC9kaXY+PGRpdj48aW1nIHNyYz0iaHR0cHM6Ly9pbWcuYWxpY2RuLmNvbS9pbWdleHRyYS9pMi8zNjMxNTgyODcvTzFDTjAxZWJXMkVQMkI1VXQxWTE2RmlfISEzNjMxNTgyODcuanBnIj48L2Rpdj48ZGl2PjxpbWcgc3JjPSJodHRwczovL2ltZy5hbGljZG4uY29tL2ltZ2V4dHJhL2kxLzM2MzE1ODI4Ny9PMUNOMDFQMVRHYWQyQjVVdDM2dklXTV8hITM2MzE1ODI4Ny5qcGciPjwvZGl2PjxkaXY+PGltZyBzcmM9Imh0dHBzOi8vaW1nLmFsaWNkbi5jb20vaW1nZXh0cmEvaTQvMzYzMTU4Mjg3L08xQ04wMWNXM3I0UzJCNVVzeVJXUDUzXyEhMzYzMTU4Mjg3LmpwZyI+PC9kaXY+PGRpdj48aW1nIHNyYz0iaHR0cHM6Ly9pbWcuYWxpY2RuLmNvbS9pbWdleHRyYS9pMi8zNjMxNTgyODcvTzFDTjAxc3JtTkJJMkI1VXN4MDRRTUNfISEzNjMxNTgyODcuanBnIj48L2Rpdj48ZGl2PjxpbWcgc3JjPSJodHRwczovL2ltZy5hbGljZG4uY29tL2ltZ2V4dHJhL2kzLzM2MzE1ODI4Ny9PMUNOMDFuUHlPM1AyQjVVc3Zpa1VIWF8hITM2MzE1ODI4Ny5qcGciPjwvZGl2PjxkaXY+PGltZyBzcmM9Imh0dHBzOi8vaW1nLmFsaWNkbi5jb20vaW1nZXh0cmEvaTIvMzYzMTU4Mjg3L08xQ04wMWx3R2Z6ZTJCNVVzdDRvcnB1XyEhMzYzMTU4Mjg3LmpwZyI+PC9kaXY+PGRpdj48aW1nIHNyYz0iaHR0cHM6Ly9pbWcuYWxpY2RuLmNvbS9pbWdleHRyYS9pMS8zNjMxNTgyODcvTzFDTjAxdWNzWlpIMkI1VXNteVRaY0lfISEzNjMxNTgyODcuanBnIj48L2Rpdj48ZGl2PjxpbWcgc3JjPSJodHRwczovL2ltZy5hbGljZG4uY29tL2ltZ2V4dHJhL2kxLzM2MzE1ODI4Ny9PMUNOMDFBblZtcWIyQjVVdDByTW8xSF8hITM2MzE1ODI4Ny5qcGciPjwvZGl2PjxkaXY+PGltZyBzcmM9Imh0dHBzOi8vaW1nLmFsaWNkbi5jb20vaW1nZXh0cmEvaTIvMzYzMTU4Mjg3L08xQ04wMUhodHVHazJCNVVzbXlUSXdmXyEhMzYzMTU4Mjg3LmpwZyI+PC9kaXY+PGRpdj48aW1nIHNyYz0iaHR0cHM6Ly9pbWcuYWxpY2RuLmNvbS9pbWdleHRyYS9pMi8zNjMxNTgyODcvTzFDTjAxbERPNHFiMkI1VXN6S29RSWNfISEzNjMxNTgyODcuanBnIj48L2Rpdj48ZGl2PjxpbWcgc3JjPSJodHRwczovL2ltZy5hbGljZG4uY29tL2ltZ2V4dHJhL2kzLzM2MzE1ODI4Ny9PMUNOMDFCWFFOazkyQjVVc3pwZUhSaF8hITM2MzE1ODI4Ny5qcGciPjwvZGl2PjxkaXY+PGltZyBzcmM9Imh0dHBzOi8vaW1nLmFsaWNkbi5jb20vaW1nZXh0cmEvaTMvMzYzMTU4Mjg3L08xQ04wMUFUcUtMSjJCNVV0Mk9EVzRRXyEhMzYzMTU4Mjg3LmpwZyI+PC9kaXY+PGRpdj48aW1nIHNyYz0iaHR0cHM6Ly9pbWcuYWxpY2RuLmNvbS9pbWdleHRyYS9pMi8zNjMxNTgyODcvTzFDTjAxTGdPRk1jMkI1VXN4MDJYdzlfISEzNjMxNTgyODcuanBnIj48L2Rpdj48ZGl2PjxpbWcgc3JjPSJodHRwczovL2ltZy5hbGljZG4uY29tL2ltZ2V4dHJhL2kyLzM2MzE1ODI4Ny9PMUNOMDFRVFZrZHEyQjVVdDByTWpxcl8hITM2MzE1ODI4Ny5qcGciPjwvZGl2PjxkaXY+PGltZyBzcmM9Imh0dHBzOi8vaW1nLmFsaWNkbi5jb20vaW1nZXh0cmEvaTIvMzYzMTU4Mjg3L08xQ04wMWhiYTlYNDJCNVV0MHJLemY4XyEhMzYzMTU4Mjg3LmpwZyI+PC9kaXY+PGRpdj48aW1nIHNyYz0iaHR0cHM6Ly9pbWcuYWxpY2RuLmNvbS9pbWdleHRyYS9pMS8zNjMxNTgyODcvTzFDTjAxVlRFUE81MkI1VXQwb0p0QVlfISEzNjMxNTgyODcuanBnIj48L2Rpdj4=
Продавец:德明旗舰店
Рейтинг:

Всего отзывов:0
Положительных:0
Выберите вариацию / цвет
Добавить в корзину
- Информация о товаре
- Фотографии
| Цвет: | SPALULA/Avocado Green [All -Inclusive Antibacterial Silicone], Sketch Spoon/Avocado Green [All -Inclusive Antibacterial Silicone], Лучший Коландер/Авокадо зеленый [все -инклюзивный антибактериальный силикон]], Rice Spoon/Avocado Green [All -Inclusive Antibacterial Silicone], Fry Shovel/Avocado Green [All -Inclusize Antibacterial Silicone], Брызг+Коландер/Фуд -ложка [три куска провинций 20 юаней], Spatling+Spoon/Spoon [три куска провинций 20 юаней], Брызг+жаркая лопата/ложка доставки [три куска провинций 20 юаней], Splason+Spoon+Salfers/Food Spoon [Четырехэлементный набор провинций 30 юаней], Пять -набор/ограниченное время [Германская пищевая оценка ✅ Высокая температура ✅ не повредит горшку ✅] |